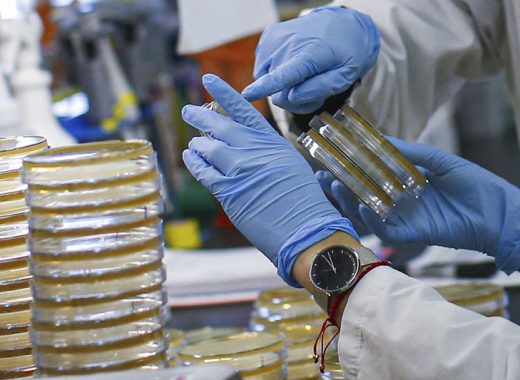
Venezuela-OPS

6 cosas que pueden salir mal en la reestructuración de la deuda, según el economista Omar Zambrano
Una reestructuración mal hecha hoy, hipoteca la posibilidad de una reestructuración bien hecha en el futuro, advierte el economista Omar Zambrano en este texto publicado originalmente en X y que reproducimos con su autorización